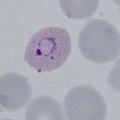

Uncategorised files
Showing below up to 50 results in range #301 to #350.
- PKET4a.jpg 472 × 472; 33 KB
- PKETc.jpg 472 × 472; 41 KB
- PKG1.jpg 472 × 472; 28 KB
- PKGc.jpg 472 × 472; 49 KB
- PKLTc.jpg 472 × 472; 50 KB
- PKSc.jpg 419 × 421; 41 KB
- PMET3g.jpg 472 × 472; 27 KB
- PMETc.jpg 472 × 472; 62 KB
- PMG1.jpg 472 × 472; 31 KB
- PMGc.jpg 473 × 472; 77 KB
- PMLTc.jpg 472 × 472; 55 KB
- PMSc.jpg 472 × 472; 57 KB
- POET1g.jpg 472 × 472; 40 KB
- POET1p.jpg 472 × 472; 40 KB
- POET2g.jpg 472 × 472; 49 KB
- POET2p.jpg 472 × 472; 49 KB
- POET3g.jpg 472 × 472; 40 KB
- POET3p.jpg 472 × 472; 40 KB
- POET4g.jpg 472 × 472; 48 KB
- POET4p.jpg 472 × 472; 48 KB
- POET main.jpg 472 × 472; 46 KB
- POETc.jpg 472 × 472; 58 KB
- POG4.jpg 472 × 472; 24 KB
- POG main.jpg 472 × 472; 202 KB
- POGc.gif 473 × 472; 116 KB
- POGc.jpg 472 × 472; 67 KB
- POLT1p.jpg 472 × 472; 55 KB
- POLT2p.jpg 472 × 472; 42 KB
- POLT3p.jpg 472 × 472; 42 KB
- POLT4p.jpg 472 × 472; 39 KB
- POLT main.jpg 472 × 472; 52 KB
- POLTc.jpg 472 × 472; 68 KB
- POS main.jpg 472 × 472; 113 KB
- POSc.jpg 472 × 472; 69 KB
- PVET1.jpg 472 × 472; 48 KB
- PVET1g.jpg 472 × 472; 48 KB
- PVET2.jpg 472 × 472; 33 KB
- PVET2g.jpg 472 × 472; 33 KB
- PVET3.jpg 472 × 472; 30 KB
- PVET3g.jpg 472 × 472; 30 KB
- PVET4.jpg 472 × 472; 43 KB
- PVET4g.jpg 472 × 472; 43 KB
- PVET main.jpg 472 × 472; 37 KB
- PVETc.jpg 472 × 472; 67 KB
- PVG1.jpg 472 × 472; 32 KB
- PVG2.jpg 472 × 472; 31 KB
- PVG3.jpg 472 × 472; 46 KB
- PVG main.jpg 472 × 472; 31 KB
- PVGc.jpg 472 × 472; 69 KB
- PVLT1.jpg 472 × 472; 42 KB